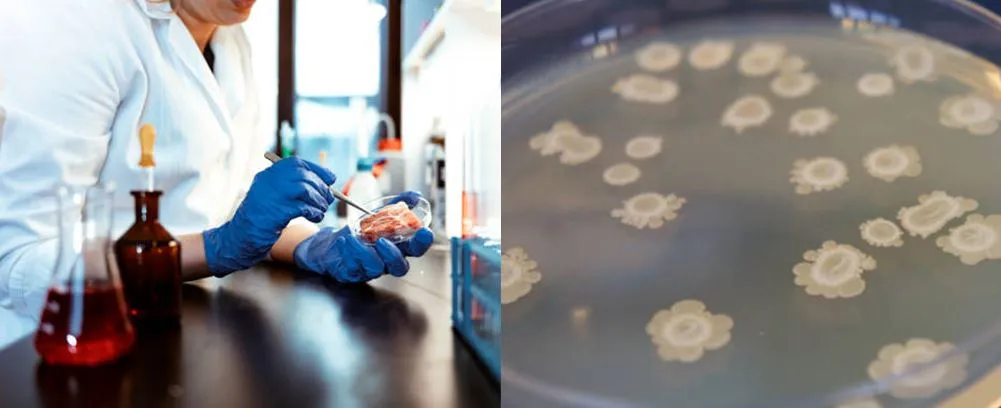

Yas Petri Tais 90mm
Yas petri phaj feem ntau yog siv pov tseg, nws tsis tuaj yeem rov siv tau thiab autoclave. Ib lub tais yas petri feem ntau hu ua cov khoom siv hluav taws xob pov tseg hauv chav kuaj. Yas petri tais muaj ib tug du nto thiab pom lub cev ntshiab.
Hauj lwm lawm
Yas Petri phaj 90mm
Yas petri phaj feem ntau yog siv pov tseg, nws tsis tuaj yeem rov siv tau thiab autoclave. Ib lub tais yas petri feem ntau hu ua cov khoom siv hluav taws xob pov tseg hauv chav kuaj. Yas petri tais muaj ib tug du nto thiab pom lub cev ntshiab.
Qhia Medlab muaj kev paub dhau los thiab kev tshaj lij hauv kev tsim cov yas petri tais diav hauv ntau qhov ntau thiab tsawg. Peb muaj petri phaj nrog kab sib chaws 60 hli, ib chav rau plaub chav petri tais hauv qhov ntau thiab tsawg thiab square loj petri tais hauv qhov zoo. Yas petri phaj yog ib qho nrov tshaj plaws hauv Guide Medlab.
|
Cov khoom npe |
yas petri tais 90mm |
|
Loj |
90m |
|
Tsis muaj menyuam |
EO lub GAMMA |
|
Sib sib zog nqus |
15 hli |
|
Ntim |
20pcs / hnab |
|
Cov duab |
Hloov |
|
Chav |
Ib/ob/peb/plaub |
● Qhov zoo
Pob tshab; Tshuaj corrosion thiab kub tsis kam.
Daim ntawv thov
Nws yog feem ntau siv hauv microbiology, kab lis kev cai ntawm tes, kab lis kev cai kab mob, biotechnology thiab tsev kawm ntawv chemistry qhia.

QTswj kev tswj

Ntim,Ciathiab kev thauj mus los
● Pob
Feem ntau, cov tais yas petri yuav tau ntim rau hauv lub hnab yas kaw tom qab ua kom tsis muaj menyuam. Nws feem ntau yog 10pcs / hnab. 500pcs / ctn.
● Cia
Cov khoom no yuav tsum tau ua tib zoo khaws cia.
● Kev thauj mus los
Nws yuav tsum tau them sai sai rau cov yas petri tais diav. Tiv thaiv kev nruj kev thauj khoom thiab tshem tawm.
Lub tuam txhab muaj zog nrog FedEx, UPS thiab DHL.

FAQ
1. Kuv puas tuaj yeem muaj cov yas petri tais hauv GAMMA sterile?
Yog lawm. Tab sis cov nqi sib txawv ntawm EO sterile.
2. Koj puas tuaj yeem pom zoo lwm yam khoom rau kev coj noj coj ua ntawm tes?
Yog lawm, koj tuaj yeem xaj cell spreader thiab Inoculation loops.
3. Koj puas muaj cov yas petri phaj tuab tuab?
Yog, peb ua.
Cim npe nrov: yas petri tais 90mm, Tuam Tshoj, lwm tus neeg, manufacturers, hoobkas, kev cai, lag luam wholesale, nqe, pricelist, dawb qauv













